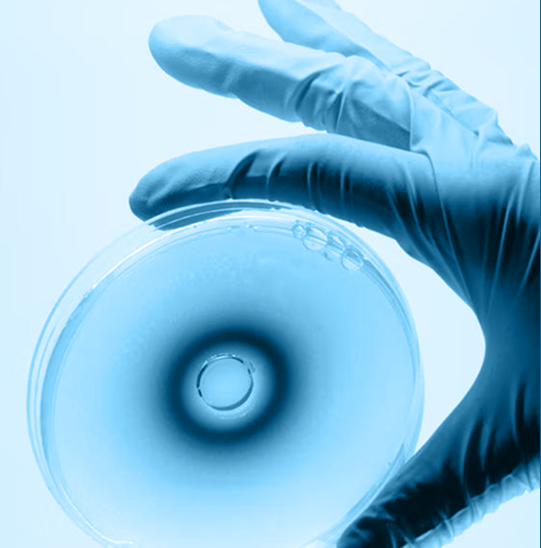
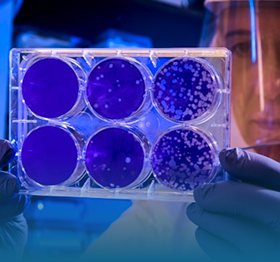
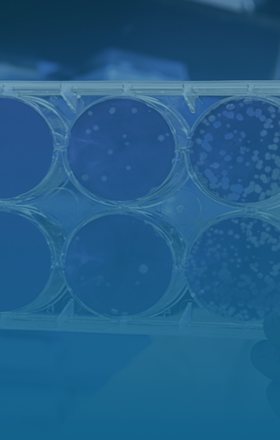

La investigación es vida, la vida es lo que importa TEST
Trabajamos por desarrollar y potenciar un espacio científico multidisciplinar en biomedicina donde se realice una investigación de excelencia y referencia en el ámbito nacional.

Trabajamos por desarrollar y potenciar un espacio científico multidisciplinar en biomedicina donde se realice una investigación de excelencia y referencia en el ámbito nacional.
Unimos el desarrollo de la docencia, la investigación científica y la tecnología en Ciencias de la Salud para liderar el progreso científico, la promoción y mejora de la asistencia sanitaria pública.

Actualmente FIBICO se encuentra ubicada en el Hospital Universitario Reina Sofía de Córdoba, siendo su ámbito de actuación esta provincia.
Nuestra misión es impulsar la investigación biomédica de excelencia

Conectar la investigación biomédica con la sociedad


Apoyar la investigación biomédica de excelencia


Promover la transferencia de conocimiento


Impulsar el talento investigador

Nuestra Misión es contribuir a situar Andalucía en la vanguardia del conocimiento científico y la innovación a nivel nacional e internacional, mediante las siguientes actividades.